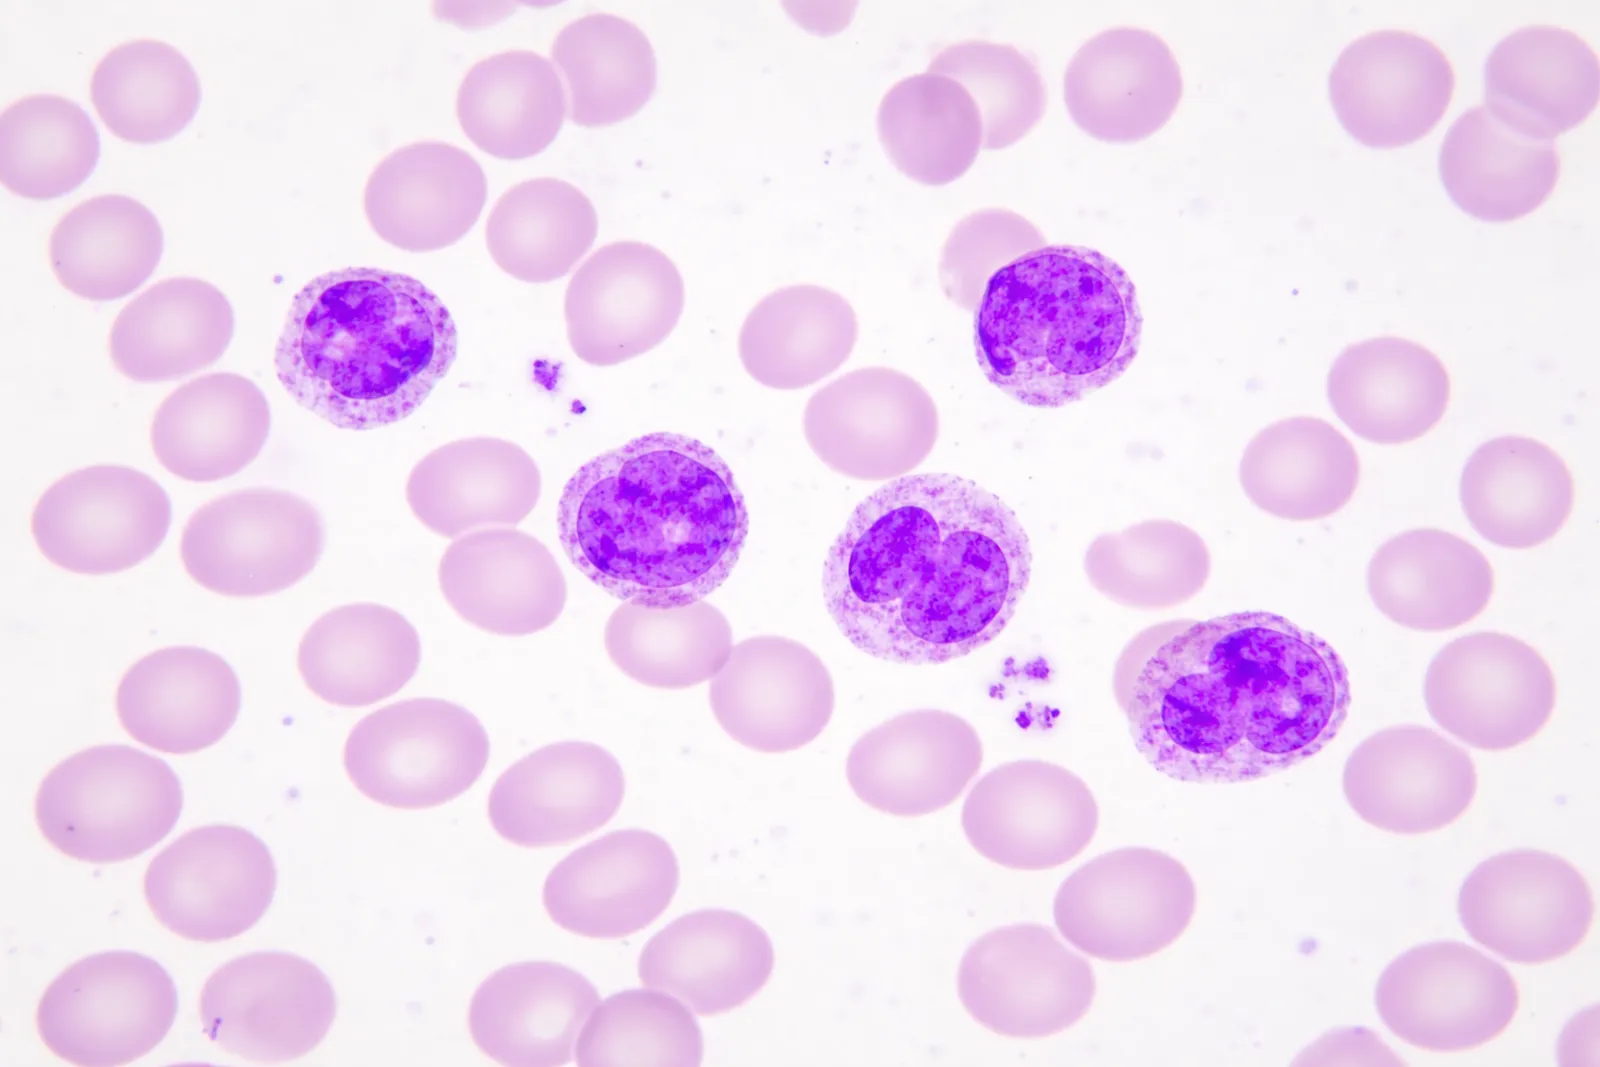
血液塗抹標本

多くの検査技師が、誰にも相談できない環境で 日々プレッシャーと戦っています。

判断に迷う細胞に遭遇。でも、周りに聞ける専門家がいない。孤独な決断の連続。

自力で学ぶ限界。正しいフィードバックが得られない環境では、スキルアップに何倍もの時間がかかる。

「見落としたらどうしよう」というプレッシャー。研修費用や移動時間など、学ぶためのコストも重荷。

教科書と実際の症例は違う。リアルな顕微鏡像を見ながら指導を受けられる機会が圧倒的に不足している。

もう、一人で悩む必要はありません。仲間とリアルタイムでつながる未来がここに。

高額な専用機器はもう不要です。お手持ちのiPhoneを顕微鏡に取り付けるだけで、驚くほど鮮明な4K映像を配信できます。
共有される映像データを、最高レベルの技術と厳格なコンプライアンス基準で保護します。
Mirelyは、場所と時間の制約を超えて、
医療現場の"困った"を解決します。
Mirelyについてのご質問にお答えします